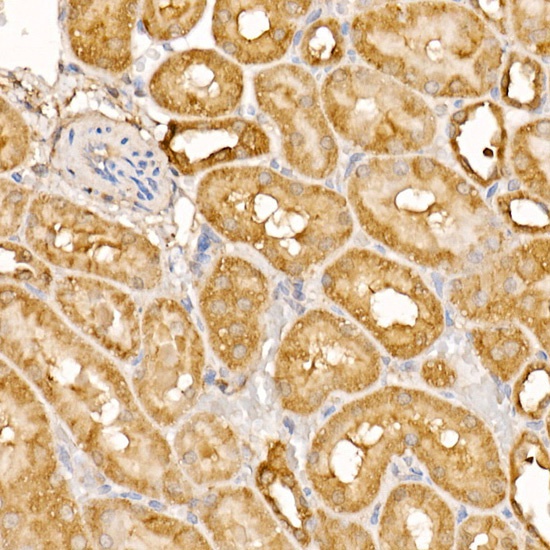
Product Image

Description
BTNL2 Antibody (CAB7120)
The BTNL2 Antibody (CAB7120) is a high-quality antibody developed for reliable detection and analysis of target proteins. This antibody, raised in rabbits, is highly reactive with human samples and has been validated for use in various applications, including Western blot analysis. By targeting the BTNL2 protein, this antibody enables the detection and analysis of BTNL2 in different cell types, making it an essential tool for studies in immunology and cancer research.
This antibody is validated for use in WB, IHC-P, ELISA applications and has demonstrated reactivity against Human, Mouse, Rat samples.
| Product Name: | BTNL2 Antibody |
| SKU: | CAB7120 |
| Size: | 20μL, 100μL |
| Reactivity: | Human, Mouse, Rat |
| Conjugate: | Unconjugated |
| Immunogen: | Recombinant protein (or fragment).This information is considered to be commercially sensitive. | ||||||
| Sequence: | LKVN GPSQ PILV RVGE DIQL TCYL SPKA NAQS MEVR WDRS HRYP AVHV YMDG DHVA GEQM AEYR GRTV LVSD AIDE GRLT LQIL SARP SDDG QYRC LFEK DDVY QEAS LDLK VVSL GSSP LITV EGQE DGEM QPMC SSDG WFPQ PHVP WRDM EGKT IPSS SQAL TQGS HGLF HVQT LLRV TNIS AVDV TCSI SIPF LGEE KIAT FSLS GW | ||||||
| Tested Applications: | WB IHC-P ELISA | ||||||
| Recommended Dilution: |
| ||||||
| Synonyms: | SS2, BTN7, BTL-II, HSBLMHC1, BTNL2 |
| Positive Sample: | 293T transfected with BTNL2 |
| Cellular Localization: | Membrane, Single-Pass Type Ii Membrane Protein. |
| Calculated MW: | 50kDa |
| Observed MW: | 65kDa |
This gene encodes a major histocompatibility complex, class II associated, type I transmembrane protein which belongs to the butyrophilin-like B7 family of immunoregulators. It is thought to be involved in immune surveillance, serving as a negative T-cell regulator by decreasing T-cell proliferation and cytokine release. The encoded protein contains an N-terminal signal peptide, two pairs of immunoglobulin-like domains, separated by a heptad peptide sequence, and a C-terminal transmembrane domain. Naturally occurring mutations in this gene are associated with sarcoidosis, rheumatoid arthritis, ulcerative colitis, inflammatory bowel disease, myositis, type 1 diabetes, systemic lupus erythematosus, acute coronary syndrome, and prostate cancer.
| Purification Method | Affinity purification |
| Gene ID | 56244 |
| RRID | AB_2767675 |
| Buffer Information | Store at -20℃. Avoid freeze / thaw cycles. Buffer: PBS containing 50% glycerol, preserved with proclin300 or sodium azide, pH 7.3. |